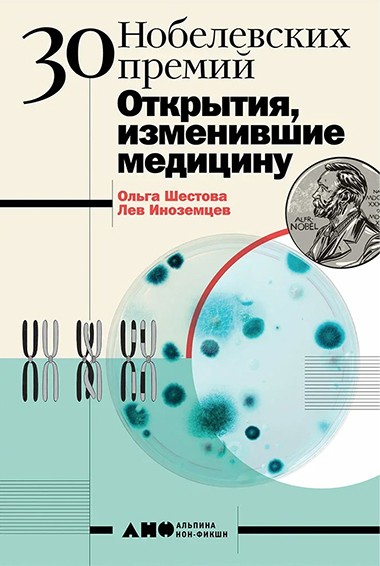

Долго и счастливо. Как ЭКО перевернуло нашу жизнь
Более 10% всех пар во всем мире не могут зачать ребенка естественным образом. Благодаря исследованиям британского ученого Роберта Эдвардса родилось более 4 млн детей.

Нобелевская премия, пожалуй, одна из самых известных наград, присуждаемых за научные исследования, в мире. Авторы книги «30 Нобелевских премий: Открытия, изменившие медицину» Ольга Шестова и Лев Иноземцев отобрали 30 открытий, повлиявших на нашу повседневную жизнь. Мы публикуем главу «ЭКО: непорочное зачатие и победа над бесплодием». Книга выходит в январе в издательстве «Альпина нон-фикшн».
Более 10% всех пар во всем мире не могут зачать ребенка естественным образом. Для большинства из них это настоящая трагедия, и долгое время репродуктивная медицина не могла помочь этим людям. Но в наши дни в случаях, когда бесплодие вызвано тем, что мужская и женская половые клетки — сперматозоид и яйцеклетка — не могут встретиться естественным путем, то есть внутри тела женщины, на помощь приходит экстракорпоральное (то есть «за пределами тела») оплодотворение. Британский ученый Роберт Эдвардс начал фундаментальное изучение биологии оплодотворения еще в 1950-х годах. Его усилия увенчались успехом 25 июля 1978 года, когда благодаря его исследованиям родился первый в мире «ребенок из пробирки». Несмотря на некоторые опасения, вскоре стало ясно, что методика ЭКО — это первая помощь бездетным парам, а «дети из пробирки» ничем не отличаются от тех, что были зачаты традиционным путем.
В 2010 году Роберту Эдвардсу была присуждена Нобелевская премия по физиологии и медицине «за разработку метода экстракорпорального оплодотворения». Благодаря фундаментальным исследованиям Эдвардса и разработке метода их практического применения родилось новое направление в медицине. А еще родились более 4 млн детей, зачатых благодаря ЭКО. Новая эра в репродуктивной медицине началась символично — с опытов Роберта Эдвардса над кроликами. Эксперименты показали, что яйцеклетки крольчих могут быть оплодотворены спермой в пробирках. Затем эмбрионы вводились в матку самки, и через положенное время у нее рождалось здоровое потомство. Эдвардс немного сомневался по поводу того, что подобный метод годится для оплодотворения женских яйцеклеток: ведь их жизненный цикл весьма отличается от кроличьего. Эдвардс вместе со своими коллегами подробнейшим образом изучил, как происходит созревание женских яйцеклеток, какие